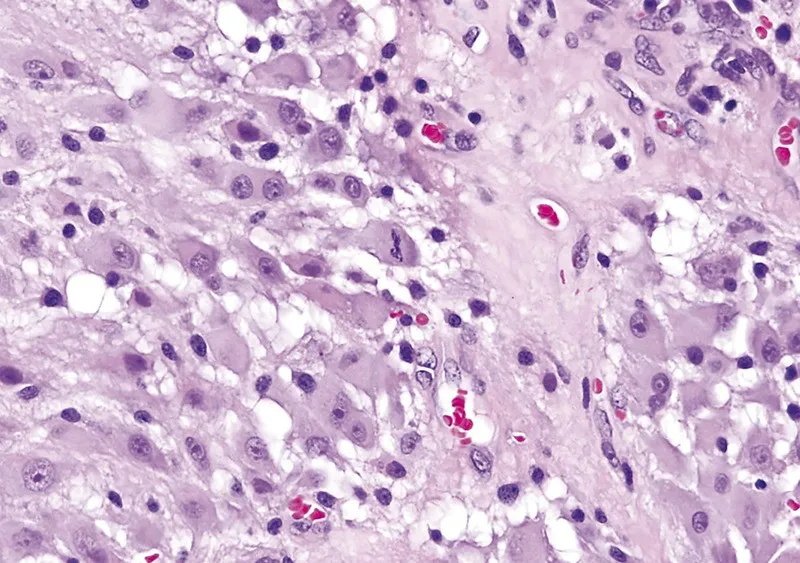
室管膜下巨细胞型星形细胞瘤
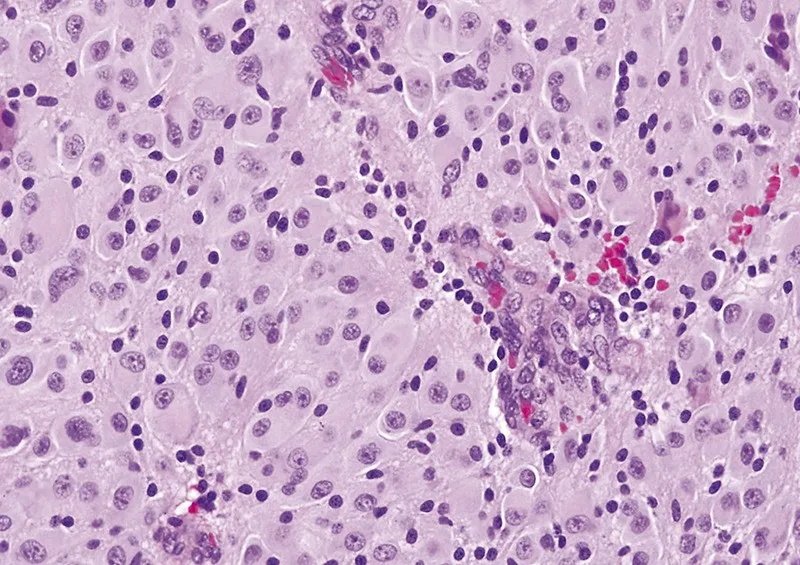
室管膜下巨细胞型星形细胞瘤

室管膜下巨细胞型星形细胞瘤(subependymal giant cellastrocytoma,SEGA)是好发于大龄儿童和青少年的一种临床少见的颅内良性神经上皮肿瘤,占儿童颅内肿瘤的1.3%~1.4%。多见于儿童结节硬化综合征患者,被认为是结节性硬化综合征的特征性表现之一。那室管膜下巨细胞型星形细胞瘤有哪些症状?发病率高吗?应该如何诊断治疗?INC脑博士科普系列为大家重点梳理,关注INC国际神经外科医生集团官方账号,后期将放送更多精彩交流。
1、室管膜下巨细胞星形细胞瘤是几级?
SEGA是WHOⅠ级良性肿瘤,全切除预后良好。
2、室管膜下巨细胞星形细胞瘤SEGA起源于哪里?
SEGAs通常起源于孟氏孔区域的室管膜下结节,可以是单侧或双侧的。SEGAs是生长缓慢的肿瘤,通常在梗阻性脑积水发生前没有症状。通过系列神经影像学上增大的大小或通过梗阻性脑积水的体征和症状与室管膜下结节相区别。在没有干预的情况下,SEGAs通常会在几周到几个月内继续缓慢增长,只有很少的证据表明衰退或增长稳定。少见地,SEGAs可表现出更具攻击性的行为,与实质侵犯或广泛的周围水肿有关,或者它们可发生在非典型部位,如松果体区或下丘脑区。它们通常伸入脑室,可引起急性或慢性脑积水。
3、室管膜下巨细胞星形细胞瘤发病率高吗?
SEGA是结节性硬化症患者中较常见的中枢神经系统肿瘤,但不确定该肿瘤是否也发生在该背景之外。SEGA在确诊的结节性硬化症患者中的发病率为5~15%,肿瘤是结节性硬化症的主要诊断标准之一。这种肿瘤通常发生于二十岁之前,在20~25岁后重新出现不常见。然而,偶尔也可以发生于婴儿,并且已经报道了几个在出生时或通过产前磁共振成像诊断的先天性病例。
4、室管膜下巨细胞星形细胞瘤症状有哪些?
多见于结节性硬化症的儿童及年轻患者(平均年龄11岁)
主要症状
(1)梗阻性脑积水
(2)由于急性颅内压增高引起的头痛、恶心、呕吐等症状
(3)由于脑室扩张引起的自发性瘤内出血少见
(4)可见逐渐加重的癫痫发作
肿瘤全切后预后良好
治疗方法:雷帕霉素和/或手术切除
5、室管膜下巨细胞星形细胞瘤影像特点有哪些?
一般表现
(1)在结节性硬化症(TSC)患者中,肿瘤好发于侧脑室室间孔附近,表现为生长缓慢的强化团块
(2)肿瘤边界明显,多呈分叶状
(3)体积多变
(4)结节性硬化症(TSC)患者中还可见皮层结节或皮层发育异常、室管膜下结节
CT
(1)相对比于灰质,呈混杂等高密度影
(2)可有钙化,或脑积水改变
(3)CT增强呈明显不均匀强化改变
MRI
(1)T1加权相:相对比于灰质,呈等低信号,钙化部分可能呈高信号
(2)T2加权相:混杂等高信号,钙化部分低信号
(3)FLAIR加权相:混杂高信号,急性脑积水和脑脊液渗入继发的室周高信号
(4)T2*/GRE/SWI:钙化部分呈现黑色的磁敏感改变
(5)T1加权增强相:明显强化
(6)DWI:对比于TSC错构瘤表现为相对低弥散

6、室管膜下巨细胞星形细胞瘤临床病理
室管膜下巨细胞星形细胞瘤属于边界清楚的星形细胞瘤,属WHO 1级。室管膜下巨细胞星形细胞瘤常为伴发于结节性硬化的少见良性星形细胞肿瘤.占结节性硬化患者的10%~15%,病理学特征为由巨噬细胞样星形细胞构成的室管膜下巨细胞星形细胞瘤与结节性硬化和错构瘤共存。肉眼所见肿瘤为边界清楚的分叶状肿块,常见钙化、囊变和丰富的血管。镜下典型者呈双核或多核星形细胞瘤,常见囊变,分化良好,可见两核或多核形成,有丝分裂少见。
CNS WHO 1级命名不因有丝分裂活性(A)、少见的微血管增生(B)或坏死(即使栅栏状)(C)而改变。
CNS WHO 1级命名不因有丝分裂活性(A)而改变。
CNS WHO 1级命名不因少见的微血管增生(B)而改变。

CNS WHO 1级命名不因坏死(即使栅栏状)(C)而改变。
7、室管膜下巨细胞星形细胞瘤和哪些疾病鉴别诊断?
本病需与其他脑室内肿瘤,如中枢神经细胞瘤、室管膜瘤、室管膜下瘤、脉络丛乳头状瘤等鉴别。
1.中枢神经细胞瘤
(1)多见于20~40岁。
(2)病变与透明隔关系密切,发生于侧脑室顶部,呈“瀑布样”改变。
(3)可见多发小囊变,呈“皂泡样”改变,钙化常见。
(4)增强扫描呈轻到中度不均匀强化。
2.室管膜瘤
(1)儿童多见,多位于四脑室,呈“钻孔样生长”。
(2)幕上室管膜瘤常发生于成人,易累及脑室旁脑实质。
(3)信号不均匀,钙化常见,增强扫描呈强化。
3.室管膜下瘤
(1)成年人多见,常无临床症状。
(2)多位于四脑室底部或侧脑室前角近孟氏孔附近。
(3)信号接近正常脑灰质,增强扫描多不强化。
4.脉络丛乳头状瘤
(1)儿童多见,侧脑室三角区为较常见发病部位。
(2)肿块呈分叶状或菜花状,钙化常见,常伴交通性脑积水。
(3)增强扫描呈不均匀强化。
8、室管膜下巨细胞星形细胞瘤怎么治疗?
治疗建议包括常规监测神经成像和密切的临床随访,特别注意急性脑积水的体征和症状。如果出现症状,或者如果系列神经成像显示肿瘤生长,建议进行神经外科手术干预。对SEGAs的标准治疗是手术切除,全切除是治愈的。如果肿瘤仍然存在,它通常会继续生长。从历史上看,手术是针对三种适应症中的一种进行的:急性脑积水,癫痫发作加重,或系列神经影像学上的间期增长。近期,一些作者主张早期手术干预以避免脑积水后遗症。
9、室管膜下巨细胞星形细胞瘤手术风险有哪些?
手术的风险包括急性发病率和长期性脑室-腹腔分流术的需要,这需与mTOR控制剂的不良作用相平衡,包括免疫控制(感染、口疮)、高胆固醇血症和长期药物监测的需要。然而,mTOR控制在结节性硬化症患者中的一些额外益处可能包括血管纤维瘤和血管平滑肌脂肪瘤的缩小以及癫痫发作负担的可能减轻。
10、室管膜下巨细胞星形细胞瘤预后怎么样?
SEGA是WHOⅠ级良性肿瘤,全切除预后良好。手术原则上应争取肿瘤全切除,根据肿瘤的位置、大小及合并脑积水情况选择合适的手术入路。对不能达到肿瘤全切除或拒绝手术的患者,伽玛刀或药物治疗可能有所帮助。但因现阶段接受治疗病例数较少,放化疗对SEGA的治疗价值仍需进一步观察。但手术仍是治疗的优选。
- 文章标题:室管膜下巨细胞型星形细胞瘤
- 更新时间:2024-06-23 21:10:44
400-029-0925




